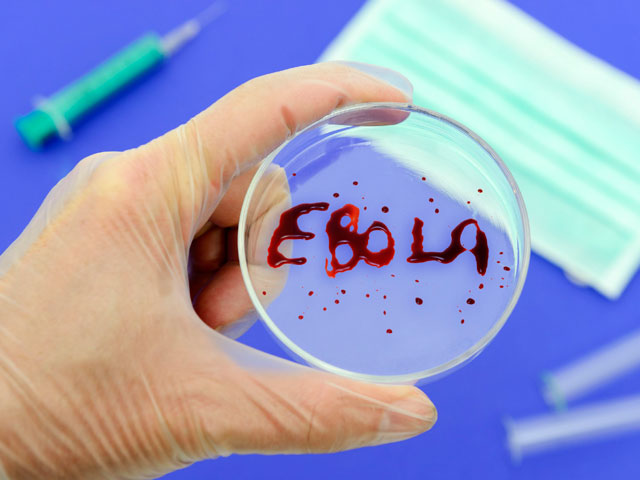

Япония предложила бороться с лихорадкой Эбола антигриппозным препаратом Favipiravir
Главный секретарь кабинета министров Японии Ёсихидэ Суга заявил, что Токио готов предоставить препарат для лечения лихорадки Эбола, который пока не был одобрен Всемирной организацией здравоохранения (ВОЗ), - Favipiravir (T-705). В марте этого года он был одобрен японскими властями как лекарство от гриппа.
По словам Суги, Favipiravir может быть передан, если на него поступят запросы, передает Reuters. "В чрезвычайных случаях мы готовы отозваться на индивидуальные запросы даже до решения ВОЗ", - рассказал главный секретарь правительства.
Favipiravir разработала японская Toyama Chemical, дочерняя компания Fujifilm Holdings Corp. Ранее ее представители утверждали, что запасов лекарства хватит более чем на 20 тысяч зараженных. В настоящее время лихорадкой инфицированы более 2,6 тысячи человек. О том, что Favipiravir, возможно, способен противодействовать Эболе, выяснилось при лабораторных работах на грызунах. В настоящее время лекарство испытывают на приматах. В середине августа ВОЗ разрешила проводить лечение от лихорадки вакцинами, которые не прошли клинических исследований.
Считается, что от Эболы, унесшей уже более 1400 жизней, не существует вакцины. Однако недавно стало известно, что от смертельного вируса вылечились двое американских врачей, заразившихся в Либерии. Кент Брэнтли и Нэнси Райтбол лечились от Эболы экспериментальным препаратом ZMapp. Пока точно неизвестно, из-за чего именно медики пошли на поправку.
Самой острой ситуация с Эболой остается в Либерии, там от лихорадки погибли более 620 человек. На Сьерра-Леону приходится почти 400 жертв лихорадки, на Гвинею - 406. В Нигерии от вируса погибли пять человек. Также случаи заражения Эболой зафиксировали и в Конго.
Кот-д'Ивуар, Габон, Сенегал, Камерун и ЮАР закрыли границы для жителей стран, где бушует лихорадка Эбола. В субботу в Сьерра-Леоне парламент принял новый закон, согласно которому укрывательство от властей больных вирусом отныне считается уголовным преступлением.
Эбола является одной из самых смертоносных болезней в мире - до 90% случаев заражения ею приводит к смерти. В числе симптомов - высокая температура, кровотечения внутренних органов и нарушения центральной нервной системы. Инкубационный период составляет от двух дней до трех недель.